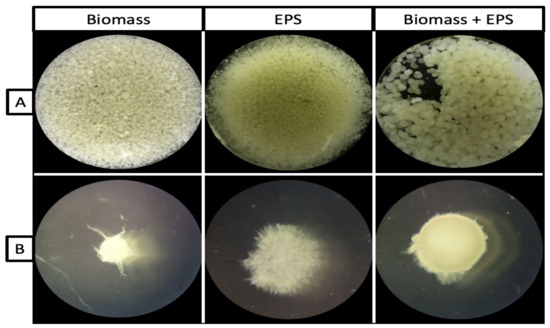

Abstract
Conventional stirred-tank bioreactor (STR) designs are optimised for cultures of bacteria but not fungal cultures; therefore, a new Air-L-Shaped Bioreactor (ALSB) was fabricated. The ALSB was designed to eliminate the wall growth and clumping of fungal mycelium in STRs. Ganoderma lucidum was used as a fungal model and its biomass and exopolysaccharide (EPS) production were maximised by optimising the agitation rate, glucose concentration, initial pH, and aeration via response surface methodology (RSM). The ALSB system generated 7.8 g/L of biomass (biomass optimised conditions: 110 rpm, 24 g/L glucose, pH 5.6, and 3 v/v of aeration) and 4.4 g/L of EPS (EPS optimised conditions: 90 rpm, 30 g/L glucose, pH 4, and 2.5 v/v of aeration). In combination, for both optimised conditions, biomass (7.9 g/L) and EPS (4.6 g/L) were produced at 110 rpm, 30 g/L glucose, pH 4, and 3 v/v of aeration with minimal wall growth. The data prove that the ALSB is a blueprint for efficient economical fungal cultivation.
1. Introduction
Fungal extracts from Ganoderma lucidum can be produced by growing the mycelium on solid media or in liquid media [1]. The extracts have been tested to determine their potential to treat chronic diseases in humans, including cancer [2]. Numerous studies have been conducted on G. lucidum to determine its medicinal abilities, which also cover the bioactive products present in it, such as the exopolysaccharides (EPS) [3,4,5,6]. Fungal biomass from G. lucidum can also be used as a bioremediation material to remove pollutants from wastewater [7].
G. lucidum can be grown via submerged liquid fermentation (SLF) to produce a mycelium pellet [8], which requires nitrogen-limiting conditions to stimulate the production of bioactive EPS [9]. The pellet utilises the nutrients in the media to produce EPS. This approach requires shorter production duration and efficiently produces more polysaccharide compared to solid state fermentation (SSF). Fungal biomass and EPS from G. lucidum have been produced via a conventional stirred-tank bioreactor (STR) [10]. However, although the process has been successfully optimised, the wall growth of the mycelium on the surface of the bioreactor reduces the efficiency of the process. STR is not good enough (low yield of biomass and polysaccharide) when applied to growing fungi due to the wall growth effect [11,12]. Fungal biomass tends to overgrow in a bioreactor, which often stops the fermentation process. This also indicates that more time and a larger work force are needed in order to perform fungal fermentation in a bioreactor [12].
The new bioreactor design used in this study may overcome the drawbacks of the existing bioreactor design for basidiomycetes and serve as a foundation for future improvements. The bioreactor was created using a fungal bioreactor design with a 2-L vessel made from thick Type 1 borosilicate glass, high-grade sterilisable plastic head space, and a stainless-steel agitation arm [13]. With biomass (g/L) and exopolysaccharide (g/L) as the main responses, the variable parameters for the novel bioreactor design (Air-L-Shaped Bioreactor; ALSB) were agitation (rpm), glucose concentration (g/L), pH, and aeration (v/v). The design could serve as a guide for commercial fungal cultivators that use fungi as their main strain of growth.
2. Materials and Methods
2.1. Mushroom Mycelium and Submerged Liquid Fermentation
The mycelium (Ganoderma lucidum strain QRS 5120) was previously identified using Supramani [11]. The mycelium was sub-cultured onto a malt extract agar (MEA) plate (working culture) and slant (stock culture) and kept at 4 °C. To perform SLF, two mycelium plugs (5 mm2) were inoculated into media composition as indicated by Supramani [11] in a 250-mL (100 mL working volume [w/v]) shake flask (first seed) for 10 days. Subsequently, the grown mycelium was blended using a sterile hand blender (Panasonic Malaysia Sdn. Bhd, MX-GS1) and 20% of the blended mycelium was used as the inoculum for a 500-mL (200 mL w/v) shake flask (second seed). The second seed culture (10 days old) was used as the inoculum (20% of total volume of ALSB) for the ALSB. The experimental range and levels of independent variables for ALSB are detailed in Table 1.

Table 1.
Experimental range and levels of independent variables.
2.2. Air-L-Shaped Bioreactor (ASLB) Design
Aeration and internal agitation are the two factors that limit shake-flask fermentation; hence, the ALSB was created to resemble a shake flask but with the properties of a bioreactor, such as controlled aeration and minimal shear stress on the mycelium [14]. The working setup of the ALSB is shown in Figure 1A and the schematic diagram is presented in Figure 1B.

Figure 1.
(A) Working setup of Air-L-Shaped Bioreactor (ALSB) with fungal culture and (B) schematic diagram of ALSB.
The stainless-steel L-shape part with dimensions of 18 cm vertically and 5 cm horizontally (similar to an upside-down bendy drinking straw) and an interior hollow portion with a diameter of 0.5 cm was designed to serve as both an agitator and a sparger. The horizontal component of the L-shape serves as a stirrer and has an integrated sparger. The top plate of the ALSB is composed of a sturdy fluoropolymer named ethylene tetrafluoroethylene (ETFE), a food-safe material that measures 10 cm in height and 12 cm in diameter. It can endure high temperatures and pressures (autoclavable). The agitation shaft and air intake were merged inside the head space and extended downward into the glass vessel as L-shaped stainless steel. In addition, four additional inlets were fitted for medium, acid, base, and glucose. To facilitate cleaning and fast repair, replacement, and upgrading processes, the inlets can be removed individually from the top head.
The glass jar is 32 cm in height and 15 cm in diameter and is constructed from high-quality borosilicate glass with 0.5 cm thickness, providing 3 L of volume and 2 L of working volume. An outlet (11.5 cm in length and 1 cm in diameter) was built into the glass tank to allow the fermentation products to be extracted without being destroyed by hydrostatic pressure [15]. A functional ALSB (50 cm in height and 15 cm in diameter), as illustrated in Figure 1A, was constructed. Numerous modifications were made to the bioreactor for a variety of purposes for different colony forming fungi or mycelia [16].
2.3. Growth Curve Comparison of Shake Flask to ALSB
The mushroom mycelium and EPS extraction was performed as indicated in method Section 2.5.1 at intervals of 2 days from day 0 until day 15.
2.4. Optimisation of ALSB Using RSM
In this study, the ALSB was optimised using response surface methodology (RSM) with the independent variables of agitation, glucose concentration, initial pH, and aeration, while the dependent variables were biomass (g/L) and exopolysaccharide (g/L) (Table 1).
2.5. Analytical Methods
2.5.1. Mycelium Biomass and Exopolysaccharide (EPS) Extraction
The mycelium biomass and EPS were extracted using the method described by Balamurugan [17] with slight modifications to the EPS extraction. The EPS extraction was performed using cold ethanol. Cold ethanol (95% [v/v]; 4 volumes) was added to the supernatant that was produced after filtering the mycelial biomass [18].
3. Results
3.1. Growth Curve Comparison of Shake Flask to ALSB
As shown in Figure 2, the standard growth curve of the ALSB is evidently higher than that of the shake flask and follows the typical fungal fermentation growth curve (exponential phase from day 5 and transition phase from day 10) [18]. The highest biomass concentration in the shake flask was 2.6 g/L on day 9 compared to 5.7 g/L for the ALSB on day 11. Meanwhile, the highest EPS in the shake flask was 1.68 g/L on day 11 compared to ALSB (3.8 g/L) on day 11. In Table 2, the total biomass and EPS yield of Ganoderma lucidum in both the shake flask and the ALSB are shown. The total biomass yield for the 15 days was 12.31 g/L in the shake flask and 33.96 g/L in the ALSB (2.8-fold higher in the ALSB). The biomass and EPS productivity in the shake flask were 0.82 and 0.548 g/L/day, respectively, whereas, for the ALSB, they were 2.264 and 1.035 g/L/day, respectively. The specific production rate of EPS in relation to biomass production was 0.045 [(g/g)/day] in the shake flask compared to 0.305 [(g/g)/day] for the ALSB. This proves that supplementary aeration in the fermentation process significantly improved the production of biomass and EPS, which is in agreement with results published in the literature [19,20,21].

Figure 2.
Growth curve of G. lucidum in shake flask compared to ALSB.

Table 2.
Total biomass and EPS yield of Ganoderma lucidum in both shake flask and ALSB.
In the innovative ALSB design, response surface methodology (RSM) was utilised to find the optimum agitation, glucose concentration, initial pH, and aeration for biomass and EPS production. The Central Composite Design (CCD) technique was utilised. Table 3 shows the independent variables and dependent variables of RSM design matrix with Central Composite Design (CCD). The coefficients were evaluated using non-linear regression analysis on a total of 30 experiments. The significance of the model coefficient (p < 0.05) was determined using analysis of variance (ANOVA) [22,23].

Table 3.
RSM design matrix with Central Composite Design (CCD) and responses utilised to optimise generation of mycelial biomass (DCW) and EPS from the mycelium of G. lucidum strain QRS 5120.
3.1.1. Optimisation of Mycelial Biomass
Table 4 displays the ANOVA for mycelium biomass production. The predicted R2 (0.88) and Adjusted R2 (0.97) show reasonable agreement; that is, the difference (0.09) is less than 0.2. Table 4 shows that the model p-value is <0.005 (p < 0.0001), which indicates a very high significance model study. This model can be used to move within the design space as the precision (S/N ratio) is sufficiently high (31.37). The model’s significance was implied by the adjusted coefficient of determination (adj. R2 = 0.97), which was regressed, as stated by Equation (1). The model’s F-value of 61.89 demonstrates the relevance of the model. An F-value this large, for 0.01% of the time, may be caused by noise. When the p-value is less than 0.05, model terms are deemed significant. In this instance, important model terms were A, B, D, AB, AD, CD, A2, B2, and D2. The 3.84 lack of fit F-value indicates that noise has a 7.54% possibility of being the cause of a big lack of fit F-value (not significant).
Biomass = −2.56930 + 0.138721 × Agitation + 0.259854 × Glucose + 0.126901 × pH − 1.72507 × Aeration − 0.000225 × Agitation × Glucose − 0.001250 × Agitation × pH + 0.004000 × Agitation × Aeration − 0.005000 × Glucose × pH − 0.006250 × Glucose × Aeration − 0.71112500 × pH × Aeration − 0.000626 × (Agitation)2 − 0.004649 × (Glucose) 2 + 0.035088 × (pH) 2 + 0.635088 × (Aeration) 2

Table 4.
The experimental results from the CCD quadratic model for biomass derived from G. lucidum strain QRS 5120 mycelia were subjected to an ANOVA.
Using the equation stated in terms of the actual factors, it is feasible to predict the reaction for certain concentrations of each element. Here, each component’s levels must be expressed in their original units. This equation should not be utilised to determine the relative importance of each factor since the coefficients are scaled to consider the units of each element and the intercept is not at the centre of the design space.
The impacts of pH, glucose concentration, agitation, and aeration are depicted in 3D graphs in Figure 3. The optimal levels of two components are shown in each panel, and the experimental ranges of the other two factors are constant. Figure 3a,b show that, in the formation of biomass, agitation was extremely significant (p = 0.0001), glucose was significant (p = 0.0048), and pH was not significant. Increasing aeration has a very high significance (0.0001) in Figure 3c. Figure 3d demonstrates that glucose was impacting production normally while pH was planar because it was not having a substantial impact. Figure 3e,f are consistent with the justification provided for Figure 3b,c.

Figure 3.
Response surface curve (3D plot) of mycelium biomass of G. lucidum obtained from ALSB showing the interaction between (a) agitation vs. glucose, (b) agitation vs. pH, (c) agitation vs. aeration, (d) glucose vs. pH, (e) aeration vs. glucose, and (f) aeration vs. pH.
3.1.2. Optimisation of EPS Production Rate
Table 5 displays the ANOVA for EPS production. The predicted R2 (0.73) and adjusted R2 (0.89) are reasonably in agreement, that is, the difference (0.16) is less than 0.2. The significance of the model is shown in Table 5 and the model p-value is < 0.005 (p < 0.0001), which indicates a very high significance model study. This model can be used to move within the design space as the precision (S/N ratio) is sufficiently high (18.01). The model’s significance was implied by the adjusted coefficient of determination (adj. R2 = 0.89), which was regressed, as stated by Equation (2). The model’s F-value of 19.14 demonstrates the relevance of the model. An F-value this large, for 0.01% of the time, may be caused by noise. When the p-value is less than 0.05, model terms are deemed significant. In this instance, important model terms were B (p < 0.0001), C (p < 0.0001), BC (p < 0.0001), and CD (p = 0.0083). The 1.37 lack of fit F-value indicates that noise has a 3.84% possibility of being the cause of a big lack of fit F-value (not significant).
EPS = −2.98107 + 0.0.17088 × Agitation + 0.0164331 × Glucose + 1.32390 × pH − 0.479423 × Aeration − 0.000162 × Agitation × Glucose + 0.000625 × Agitation × pH − 0.001125 × Agitation × Aeration − 0.031875 × Glucose × pH − 0.005625 × Glucose × Aeration − 0.143750 × pH × Aeration − 0.000069 × (Agitation)2 + 0.001772 × (Glucose)2 − 0.072807 × (pH)2 + 0.127193 × (Aeration)2

Table 5.
The experimental results from the CCD quadratic model for EPS derived from G. lucidum strain QRS 5120 mycelia were subjected to an ANOVA.
Using Equation (2), in terms of the real factors, it is possible to predict the reaction for certain levels of each element. Here, each component’s levels must be expressed in their original units. This equation should not be used to determine the relative importance of each factor because the coefficients are scaled to consider the units of each element and the intercept is not at the centre of the design space.
The impact of pH, glucose concentration, agitation, and aeration are depicted in 3D graphs in Figure 4. The optimal levels of two components are shown, and the experimental ranges of the other two factors are fixed. Figure 4a,b show that, in the formation of EPS, glucose concentration was extremely significant (p < 0.0001), agitation was not significant (p < 0.4260) and pH was extremely significant (p < 0.0001). Figure 4c indicates that there are no significant effects on EPS production from agitation and aeration. Figure 4d demonstrates that glucose and pH were extremely significant (p < 0.0001). Figure 4e shows that glucose was significant but aeration was not, while Figure 4f shows that pH was significant but aeration was not.

Figure 4.
Response surface curve (3D plot) for exopolysaccharide (EPS) production of G. lucidum obtained from ALSB showing the interactions between (a) agitation and glucose, (b) agitation and pH, (c) agitation and aeration, (d) glucose and pH, (e) aeration and glucose, and (f) aeration and pH.
3.2. Verification of Optimised Conditions
The optimised conditions produced by RSM were verified, and the results are shown in Table 6; Additionally, the pellet morphology is illustrated in Figure 5. Verification was performed to confirm the strength and precision of the optimisation under Equations (1) and (2). Upon verification, it was found that the optimisation and the new bioreactor design significantly increased the production of biomass and EPS.

Table 6.
Verification of model with optimised conditions.
Figure 5.
Macroscopic (A) and microscopic (B) morphological analysis of mycelium pellets in optimised media conditions for each response.
3.3. Comparison of ALSB with Commercially Used Bioreactor and Shake Flask
The optimised production of biomass and EPS using G. lucidum in the newly designed bioreactor was compared with other cultivation modes, as shown in Table 7. The study conducted by Supramani [11] reported an optimised production of mycelium biomass of 5.19 g/L and polysaccharides (both EPS [2.64 g/L] and IPS [2.64 g/L]). The study conducted by Bamigboye [24] only showed very low biomass (0.7 g/L) production upon optimising; however, EPS (0.29 g/L) was not significantly improved. Meanwhile, another study conducted by Guo [25] in conventional STR using a faster species Phellinus igniarius generated 13.86 g/L of biomass but with a low level of EPS at 1.92 g/L and suspected strong wall growth. In our ALSB cultivation system, the production of both biomass (7.9 g/L) and EPS (4.6 g/L) were significantly increased. Similar conditions were tested in a conventional STR-Bioreactor, giving lower production of biomass (6.5 g/L) and EPS (3.9 g/L) compared to the ALSB. Moreover, according to [26] and [27], wall growth is a major issue encountered in most fungal pelleted bioreactors, which was almost eradicated for G. lucidum in ALSB.

Table 7.
Comparison of ALSB optimisation using submerged liquid fermentation in a different cultivation method with literature.
In contrast to traditional STR (Figure 6B), the mycelium culture of G. lucidum in Figure 6A (ALSB) exhibits almost no wall growth. In contrast, the wall growth was substantial in the traditional STR (Figure 6B). An STR includes optional baffles; however, even without them, the pH probe, DO probe, sample port, and sparger create pseudo-resistance that the fungus’s mycelium can latch onto. This observation is consistent with the study reported in Larson [28], which established that 30% of the biomass produced by traditional laboratory scale bioreactors is attached to the walls. Thus, the newly developed bioreactor (ALSB) was more suited for fungal fermentation compared to commercial bioreactors. In this work, the most recent critical parameters for G. lucidum using a novel bioreactor system (ALSB) are presented. For efficient biomass and EPS formation, these parameters include pH, glucose concentration, agitation, and aeration. This new blueprint for industrial-scale fungal fermentation can be applied to larger, more specialised bioreactors.

Figure 6.
Differences in mycelium culture between ALSB (A) and commercially used STR-Bioreactor (B) for comparison study using the verified optimised conditions.
4. Discussions
As part of any research using microorganisms, the growth phases must be identified to understand the nature of its growth. The growth curve in a shake flask was previously reported [11]. Based on the previous study, the maximum duration of the fermentation was known. Using similar parameters, the growth curve in the ALSB was determined. The results showed a significant increment in both biomass and EPS production in the ALSB compared to the shake flask. A study conducted by Rodrigues [29] on S. cerevisiae for protein production showed that oxygen is crucial during the induction phase, which was also supported by [30]. In ALSB, the induction phase was supplied with oxygen (air); however, due to the limitation of shake-flask fermentation, aeration was not performed. This could be the reason for the higher biomass and EPS production in the ALSB compared to the shake flask.
Moreover, it has also been shown that the morphology of the fungal pellet is affected by dissolved oxygen [31]. The mycelium pellet showed internal degradation due to the poor oxygen transfer rate within the mycelium pellet. According to [21], the hollow structure is caused by the degradation of the mycelium inside the mycelium pellet due to insufficient oxygen and nutrients, which is in agreement with [31]. This issue was eliminated in the ALSB as the mycelium does not form a large pellet with a hollow structure. This allows more uniform nutrient uptake by the fungus and a higher production of EPS, which is shown in Table 2. Our comparison between shake flask and ALSB culturing clearly shows the advantages of the ALSB over the shake flask.
Therefore, optimisation was performed to further optimise the conditions specifically for G. lucidum. To optimise the fermentation conditions in ALSB for G. lucidum, response surface methodology (RSM) was used. RSM uses statistical analysis to indicate the optimised conditions with minimal experimental runs. In this study, by only performing 30 runs with different independent variables, as produced by RSM, the optimised conditions for each of the dependent variables independently and in combination were obtained as shown in Table 5. A previous study conducted by Supramani [11] also showed the advantages of RSM over other optimisation methods. Another study conducted by Balamurugan [17] also used RSM in order to obtain optimised conditions for Serbian Ganoderma applanatum in 30 runs for four independent variables. Ahmad [32] conducted a study to optimise the medium components for the fermentation of Lentinus squarrosulus in just 20 runs of experiments for three independent variables, similar to [23]. The main use of RSM is to reduce the number of experimental runs while producing results that are better than those obtained using the one-factor-at-a-time method with graphical representation [33]. By performing a quadratic regression on the experiments, the interactions between the independent variables were identified and their significance to each other was studied, as shown in Table 3 and Table 4. Upon optimising the medium conditions, verification was performed to verify the integrity of this study, as shown in Table 5.
During the verification, the mycelium morphology was observed both macroscopically and microscopically. A small, compact pellet produced more biomass while a hairy starburst pellet produced higher EPS, and a slightly larger compact hairy pellet produced high biomass and EPS. This result is in agreement with those reported in the literature [8,11,17,18,23]. Small, compact pellets have closely packed mycelium, which increases their weight, whereas the hairy starburst pellets have a higher surface area for nutrient and oxygen uptake and also EPS secretion into the liquid medium, which is in agreement with [34]. Upon verification of the statistical model, it was tested on a commercially available bioreactor, as shown in Table 7 and Figure 6. The commercially used bioreactor is not suitable for fungal liquid fermentation due to clumping issues. Larsen [28] studied the wall growth of Aspergillus oryzae but could not achieve complete eradication. In this study, as shown in Figure 6B, the standard bioreactor had much more wall growth compared to the ALSB (Figure 6A).
The principle of the ALSB is to maximise the biomass and EPS production by minimising the overgrowth/wall growth of mycelium. In the design of the ALSB, no sharp corners were introduced in any part of the vessel that is in contact with the fermentation media. This is mainly done to prevent the mycelium from anchoring to the corners, where a mass of mycelium would build up. Such limitation of the mycelium mass build-up was also observed in the study conducted by Larsen and Fazenda [21,28]. This affected the production rate as the process has to be stopped in order to clean the bioreactor and remove such build-ups [12]. Apart from that, the oxygen transfer rate was also affected within the mycelium due to mycelium mass build-up, which releases unwanted toxins into the fermentation media [21]. In addition, the size of the bubbles formed during fermentation is significant; a bubble size lower than 3 mm2 contributes to foaming [35], which encourages the mycelium to grow on the foam as well. This is prevented in the ALSB as the 5 mm hollow sparger produces bubbles larger than 29 mm2 [36]. The ALSB has been shown to be more suitable for fungal liquid fermentation than the standard bioreactor system.
5. Conclusions
The G. lucidum was successfully cultivated in a novel ALSB with minimal wall growth with the optimised conditions of pH 4, 30 g/L of glucose, 110 rpm, and 3 v/v aeration. ALSB boosted the biomass (7.9 g/L) and EPS (4.6 g/L) production by 1.2-fold compared to the stirred-tank bioreactor (biomass: 6.5 g/L and EPS: 3.9 g/L). This new bioreactor blueprint provides an efficient and economical fungal liquid cultivation system as opposed to expensive commercial bioreactors.
Author Contributions
Conceptualization, S.S. and W.A.A.Q.I.W.-M.; methodology, R.A. and S.S.; software, P.-L.S. and M.F.I.; validation, N.A.R., Z.I. and W.A.A.Q.I.W.-M.; formal analysis, S.S. and R.A.; investigation, S.S. and N.A.R.; resources, Z.I. and W.A.A.Q.I.W.-M.; data curation, S.S. and R.A.; writing—original draft preparation, S.S. and W.A.A.Q.I.W.-M.; writing—review and editing, P.-L.S. and M.F.I.; visualization, S.S.; supervision, N.A.R., Z.I. and W.A.A.Q.I.W.-M.; project administration, N.A.R., Z.I. and W.A.A.Q.I.W.-M.; funding acquisition, N.A.R., Z.I. and W.A.A.Q.I.W.-M. All authors have read and agreed to the published version of the manuscript.
Funding
This research was funded by Malaysian Ministry of Higher Education (FRGS/1/2018/STG05/UM/02/7) (FRGS: FP066-2018A), RU-Grant Faculty Program- Universiti Malaya (GPF084A: GPF084B—2020) and USIM [PPPI/UGC_0119/KPI/051000/11919.
Institutional Review Board Statement
Not applicable.
Informed Consent Statement
Not applicable.
Data Availability Statement
The raw data are available upon request.
Acknowledgments
We would like to thank the Ministry of Higher Education (MOHE) for granting via Fundamental Research Grant Scheme and RU-Grant Faculty Program-Universiti Malaya. Final thanks to Geran Penyelidikan USIM.
Conflicts of Interest
The authors declare no conflict of interest.
References
- Shi, C.-F.; Yang, H.-T.; Chen, T.-T.; Guo, L.-P.; Leng, X.-Y.; Deng, P.-B.; Bi, J.; Pan, J.-G.; Wang, Y.-M. Artificial neural network-genetic algorithm-based optimization of aerobic composting process parameters of Ganoderma lucidum residue. Bioresour. Technol. 2022, 357. [Google Scholar] [CrossRef]
- Kozarski, M.; Klaus, A.; van Griensven, L.; Jakovljevic, D.; Todorovic, N.; Wan-Mohtar, W.A.A.Q.I.; Vunduk, J. Mushroom β-glucan and polyphenol formulations as natural immunity boosters and balancers: Nature of the application. Food Sci. Hum. Wellness 2023, 12, 378–396. [Google Scholar] [CrossRef]
- Papinutti, L. Effects of nutrients, pH and water potential on exopolysaccharides production by a fungal strain belonging to Ganoderma lucidum complex. Bioresour. Technol. 2010, 101, 1941–1946. [Google Scholar] [CrossRef]
- Abdullah, N.R.; Nasir, M.H.M.; Azizan, N.H.; Wan-Mohtar, W.A.A.Q.I.; Sharif, F. Bioreactor-grown exo- and endo-β-glucan from Malaysian Ganoderma lucidum: An in vitro and in vivo study for potential antidiabetic treatment. Front. Bioeng. Biotechnol. 2022, 10. [Google Scholar] [CrossRef]
- Usuldin, S.R.A.; Wan-Mohtar, W.A.A.Q.I.; Ilham, Z.; Jamaludin, A.A.; Abdullah, N.R.; Rowan, N. In vivo toxicity of bioreactor-grown biomass and exopolysaccharides from Malaysian tiger milk mushroom mycelium for potential future health applications. Sci. Rep. 2021, 11, 1–13. [Google Scholar] [CrossRef]
- Revankar, M.S.; Lele, S. Synthetic dye decolorization by white rot fungus, Ganoderma sp. WR-1. Bioresour. Technol. 2007, 98, 775–780. [Google Scholar] [CrossRef]
- Mooralitharan, S.; Hanafiah, Z.M.; Manan, T.S.B.A.; Hasan, H.A.; Jensen, H.S.; Wan-Mohtar, W.A.A.Q.I.; Mohtar, W.H.M.W. Optimization of Mycoremediation Treatment for the Chemical Oxygen Demand (COD) and Ammonia Nitrogen (AN) Removal from Domestic Effluent Using Wild-Serbian Ganoderma lucidum (WSGL). Environ. Sci. Pollut. Res. 2021, 28, 32528–32544. [Google Scholar] [CrossRef]
- Abdullah, N.R.; Sharif, F.; Azizan, N.H.; Hafidz, I.F.M.; Supramani, S.; Usuldin, S.R.A.; Ahmad, R.; Wan-Mohtar, W.A.A.Q.I. Pellet diameter of Ganoderma lucidum in a repeated-batch fermentation for the trio total production of biomass-exopolysaccharide-endopolysaccharide and its anti-oral cancer beta-glucan response. AIMS Microbiol. 2020, 6, 379–400. [Google Scholar] [CrossRef]
- Zhao, W.; Xu, J.-W.; Zhong, J.-J. Enhanced production of ganoderic acids in static liquid culture of Ganoderma lucidum under nitrogen-limiting conditions. Bioresour. Technol. 2011, 102, 8185–8190. [Google Scholar] [CrossRef]
- Jahis, B.M.M.; Ilham, Z.; Supramani, S.; Sohedein, M.N.A.; Ibrahim, M.F.; Abd-Aziz, S.; Rowan, N.; Wan-Mohtar, W.A.A.Q.I. Ganodiesel: A New Biodiesel Feedstock from Biomass of the Mushroom Ganoderma lucidum. Sustainability 2022, 14, 10764. [Google Scholar] [CrossRef]
- Supramani, S.; Ahmad, R.; Ilham, Z.; Annuar, M.S.M.; Klaus, A.; Wan-Mohtar, W.A.A.Q.I. Optimisation of biomass, exopolysaccharide and intracellular polysaccharide production from the mycelium of an identified Ganoderma lucidum strain QRS 5120 using response surface methodology. AIMS Microbiol. 2019, 5, 19–38. [Google Scholar] [CrossRef]
- Moreira, M.; Feijoo, G.; Lema, J. Fungal Bioreactors: Applications to White-rot Fungi. Rev. Environ. Sci. Biotechnol. 2003, 2, 247–259. [Google Scholar] [CrossRef]
- Moreira, F.S.; Machado, R.G.; Romão, B.B.; Batista, F.R.X.; Ferreira, J.S.; Cardoso, V.L. Improvement of hydrogen production by biological route using repeated batch cycles. Process. Biochem. 2017, 58, 60–68. [Google Scholar] [CrossRef]
- Sundaramurthy, S. Mixing in Shake Flask Bioreactor. In Encyclopedia of Industrial Biotechnology: Bioprocess, Bioseparation, and Cell Technology; Flickinger, M.C., Ed.; John Wiley & Sons, Inc.: Hoboken, NJ, USA, 2016. [Google Scholar]
- Rosser, J.; Thomas, D.J. Bioreactor processes for maturation of 3D bioprinted tissue. In 3D Bioprinting for Reconstrutive Surgery; Thomas, D.J., Jessop, Z.M., Whitaker, I.S., Eds.; Elsevier: Amsterdam, The Netherlands, 2018; pp. 191–215. [Google Scholar]
- Gaikwad, V.; Panghal, A.; Jadhav, S.; Sharma, P.; Bagal, A.; Jadhav, A.; Chhikara, N. Designing of Fermenter and Its Utilization in Food Industries. Preprints 2018. [Google Scholar] [CrossRef]
- Balamurugan, J.P.; Supramani, S.; Usuldin, S.R.A.; Ilham, Z.; Klaus, A.; Ikram, N.K.K.; Ahmad, R.; Wan-Mohtar, W.A.A.Q.I. Efficient biomass-endopolysaccharide production from an identified wild-Serbian Ganoderma applanatum strain BGS6Ap mycelium in a controlled submerged fermentation. Biocatal. Agric. Biotechnol. 2021, 37, 102166. [Google Scholar] [CrossRef]
- Supramani, S.; Jailani, N.; Ramarao, K.; Zain, N.A.M.; Klaus, A.; Ahmad, R.; Wan-Mohtar, W.A.A.Q.I. Pellet diameter and morphology of European Ganoderma pfeifferi in a repeated-batch fermentation for exopolysaccharide production. Biocatal. Agric. Biotechnol. 2019, 19, 101118. [Google Scholar] [CrossRef]
- Wan-Mohtar, W.A.A.Q.I.; Ab Kadir, S.; Saari, N. The morphology of Ganoderma lucidum mycelium in a repeated-batch fermentation for exopolysaccharide production. Biotechnol. Rep. 2016, 11, 2–11. [Google Scholar] [CrossRef]
- Wan-Mohtar, W.A.A.Q.I.; Malek, R.A.; Harvey, L.M.; McNeil, B. Exopolysaccharide production by Ganoderma lucidum immobilised on polyurethane foam in a repeated-batch fermentation. Biocatal. Agric. Biotechnol. 2016, 8, 24–31. [Google Scholar] [CrossRef]
- Fazenda, M.L. Effects of Dissolved Oxygen on Fungal Morphology and Process Rheology During Fed-Batch Processing of Ganoderma lucidum. J. Microbiol. Biotechnol. 2010, 20, 844–851. [Google Scholar] [CrossRef]
- Papaspyridi, L.-M.; Katapodis, P.; Gonou-Zagou, Z.; Kapsanaki-Gotsi, E.; Christakopoulos, P. Optimization of biomass production with enhanced glucan and dietary fibres content by Pleurotus ostreatus ATHUM 4438 under submerged culture. Biochem. Eng. J. 2010, 50, 131–138. [Google Scholar] [CrossRef]
- Hassan, N.A.; Supramani, S.; Sohedein, M.N.A.; Usuldin, S.R.A.; Klaus, A.; Ilham, Z.; Chen, W.-H.; Wan-Mohtar, W.A.A.Q.I. Efficient biomass-exopolysaccharide production from an identified wild-Serbian Ganoderma lucidum strain BGF4A1 mycelium in a controlled submerged fermentation. Biocatal. Agric. Biotechnol. 2019, 21, 101305. [Google Scholar] [CrossRef]
- Bamigboye, C.O.; Oloke, J.K.; Burton, M.; Dames, J.F.; Lateef, A. Optimization of the Process for Producing Biomass and Exopolysaccharide from the King Tuber Oyster Mushroom, Pleurotus tuber-regium (Agaricomycetes), for Biotechnological Applications. Int. J. Med. Mushrooms 2019, 21, 311–322. [Google Scholar] [CrossRef]
- Guo, X.; Zou, X.; Sun, M. Optimization of a chemically defined medium for mycelial growth and polysaccharide production by medicinal mushroom Phellinus igniarius. World J. Microbiol. Biotechnol. 2009, 25, 2187–2193. [Google Scholar] [CrossRef]
- Musoni, M.; Destain, J.; Thonart, P.; Bahama, J.-B.; Delvigne, F. Bioreactor design and implementation strategies for the cultivation of filamentous fungi and the production of fungal metabolites: From traditional methods to engineered systems. Biotechnol. Agron. Soc. Environ. 2015, 19, 430–442. [Google Scholar]
- Espinosa-Ortiz, E.J.; Rene, E.R.; Pakshirajan, K.; van Hullebusch, E.D.; Lens, P.N. Fungal pelleted reactors in wastewater treatment: Applications and perspectives. Chem. Eng. J. 2016, 283, 553–571. [Google Scholar] [CrossRef]
- Larsen, B.; Poulsen, B.R.; Eriksen, N.T. Homogeneous batch cultures of Aspergillus oryzae by elimination of wall growth in the Variomixing bioreactor. Appl. Microbiol. Biotechnol. 2003, 64, 192–198. [Google Scholar] [CrossRef]
- Rodrigues, D.; Pillaca-Pullo, O.; Torres-Obreque, K.; Flores-Santos, J.; Sanchez-Moguel, I.; Pimenta, M.V.; Basi, T.; Converti, A.; Lopes, A.M.; Monteiro, G. Fed-Batch Production of Saccharomyces cerevisiae L-Asparaginase II by Recombinant Pichia pastoris MUT s Strain. Front. Bioeng. Biotechnol. 2019, 7, 16. [Google Scholar] [CrossRef]
- Lim, H.-K.; Choi, S.-J.; Kim, K.-Y.; Jung, K.-H. Dissolved-oxygen-stat controlling two variables for methanol induction of rGuamerin in Pichia pastoris and its application to repeated fed-batch. Appl. Microbiol. Biotechnol. 2003, 62, 342–348. [Google Scholar] [CrossRef]
- Fazenda, M.L.; Seviour, R.; McNeil, B.; Harvey, L.M. Submerged Culture Fermentation of “Higher Fungi”: The Macrofungi. Adv. Appl. Microbiol. 2008, 36, 33–103. [Google Scholar] [CrossRef]
- Ahmad, R.; Al-Shorgani, N.K.N.; Hamid, A.A.; Yusoff, W.M.W.; Daud, F. Optimization of medium components using response surface methodology (RSM) for mycelium biomass and exopolysaccharide production by Lentinus squarrosulus. Adv. Biosci. Biotechnol. 2013, 4, 1079–1085. [Google Scholar] [CrossRef]
- Joshi, V.K.; Chauhan, A.; Devi, S.; Kumar, V. Application of response surface methodology in optimization of lactic acid fermentation of radish: Effect of addition of salt, additives and growth stimulators. J. Food Sci. Technol. 2014, 52, 4935–4944. [Google Scholar] [CrossRef][Green Version]
- Büchs, J. Introduction to advantages and problems of shaken cultures. Biochem. Eng. J. 2001, 7, 91–98. [Google Scholar] [CrossRef]
- Junker, B. Foam and Its Mitigation in Fermentation Systems. Biotechnol. Progr. 2007, 23, 767–784. [Google Scholar] [CrossRef]
- Wang, H.Y.; Dong, F. A method for bubble volume calculating in vertical two-phase flow. J. Physics Conf. Ser. 2009, 147. [Google Scholar] [CrossRef]
Disclaimer/Publisher’s Note: The statements, opinions and data contained in all publications are solely those of the individual author(s) and contributor(s) and not of MDPI and/or the editor(s). MDPI and/or the editor(s) disclaim responsibility for any injury to people or property resulting from any ideas, methods, instructions or products referred to in the content. |
© 2023 by the authors. Licensee MDPI, Basel, Switzerland. This article is an open access article distributed under the terms and conditions of the Creative Commons Attribution (CC BY) license (https://creativecommons.org/licenses/by/4.0/).